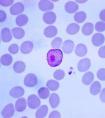

新闻资讯
本专题为癌症123的癌症专题,内容全部来自癌症123精心选择与癌症相关的最近资讯,癌症123读懂智能与未来,拥有癌症资讯的信息,在这里你能看到未来的世界。
*以上解读内容仅供参考,癌症123不对解读内容负责。
癌症基因组图谱 Nature 发文,揭示宫颈癌基因组特征
2017-01-252017 年 1 月 23 日发表在《 Nature 》上的研究显示,美国癌症基因组图谱( TCGA )计划的科学家们确定了宫颈癌新的基因组和分子特征,这将有助于疾病的分类,推动靶向治疗,帮助每个患者找到最合...
阿斯利康改变肿瘤免疫治疗实验目标!肺癌免疫治疗竞争激烈
2017-01-24——阿斯利康(AZ)在一项关于该公司肿瘤免疫学药物durvalumab和tremelimumab的肺癌临床试验中设定了一个新目标,想在这一领域领先其竞争对手。这个英国药物制造商在一项MYSTIC临床试验...
Science子刊:揭示出癌症免疫疗法新靶标---TNFR2
2017-01-24在一项新的研究中,来自美国麻省总医院(MGH)的研究人员发现新的证据证实肿瘤坏死因子受体II(TNFR2)可能是免疫肿瘤学疗法(诱导病人免疫系统抵抗癌症)的一种主要靶标。TNFR2在很多类型的癌细...
Nature:附带致死性或有助开发出治疗胰腺癌的新方法
2017-01-24癌细胞经常剔除在正常情形下抑制肿瘤形成的基因。这些基因剔除可能也会影响相邻的基因,这一事件被称作为“附带致死性(collateral lethality)”。这可能为开发治疗几种癌症的疗法提供新...
上海硅酸盐所实现不用有毒化学药物的肿瘤特异性化疗
2017-01-24硅化镁纳米颗粒诱导肿瘤饥饿治疗原理图 众所周知,癌症化疗中,需要使用高毒性的化疗药物。由于药物的非特异性,在杀死癌细胞的同时,同样杀死正常细胞,损害正常的组织...
抓住“潜逃”基因,科学家发现潜在的胃肠道癌症治疗靶标
2017-01-24像潜逃的银行抢劫逃犯一样,Gpr182 在几十年来伪装了各种身份:G10D,HrhAMR,Gamrh,7TMR,ADMR。它编码的蛋白质被称为“孤儿”受体,在细胞表面上并没有钥匙来进行解锁,这让...
“关闭” 癌细胞中的错误基因,解决癌细胞的抗药性
2017-01-23【科学家发现癌细胞抗药根源,有望推动癌症治疗】日前,一项与基因有关的血癌发展研究解释了为什么在使用普通抗癌药治疗时会出现抵抗性。 道格拉斯大学的研究团队发现一种称为 RUNX1 的基...
科学家抓住了潜逃的“犯罪”基因,向开发癌症新药迈出一大步
2017-01-23近期,发表于《临床医学》杂志上的一篇文章中写道,科学家们终于抓住了 Gpr182。多年来,Gpr182 就像是在逃的罪犯一样,让科学家们束手无策。研究表明,如果可以找到解决...
以瘤之盾,治瘤之矛:新研究开发出更安全有效的CAR-T疗法!
2017-01-23在像柔道这样的武术中,武士会将对方的力量转回给对方,从而将他们自己的力量增大。而在T细胞与肿瘤细胞的斗争中,T细胞的免疫攻击常常由于肿瘤产生的免疫抑制信号而削弱。这些信号...
Cancer Discovery:科学家发现侵袭性乳腺癌抵抗药物新机制
2017-01-23在一项新研究中,研究人员发现了一种侵袭性乳腺癌抵抗药物治疗的新机制,并找到能够阻止癌症生长帮助防止药物抵抗发生的一种潜在药物组合。来自美国北卡罗来纳大学的研究人员将他们...
癌受体蛋白结构得到解析,为药物开发铺平道路
2017-01-23-凯斯西储大学医学院的研究人员最近揭示了一种癌细胞受体蛋白的结构,未来有望用于开发对抗疾病进展的新药物。之前研究已经证明阻断该受体能够延缓一些肿瘤类型的生长和转移,但是因...
PNAS:微环境改变胰腺癌细胞表观遗传和代谢 科学家找到解决方法
2017-01-23就像种子生长需要营养和水分充分的土壤一样,许多癌症都依赖于周围的环境才能在体内繁荣生长。肿瘤微环境在肿瘤生长过程中发挥重要作用。现在科学家们发现了来自微环境的信号如何...
JCB:关闭错误基因或可逆转血液癌症对类固醇药物的抵抗
2017-01-23最近一项新研究揭示了为何有些血液癌症病人会抵抗癌症治疗中所使用的类固醇药物,比如地塞米松。来自英国格拉斯哥大学的科学家们发现RUNX1基因的异常活性会干扰信号分子的作用从而...
PNAS:利用循环肿瘤细胞提高对肝癌的诊断和监测
2017-01-23利用一种高级PCR技术分析循环肿瘤细胞或可大大提高对早期阶段癌症的诊断能力。在这篇发表在国际学术期刊PNAS上的文章中,来自麻省总医院癌症中心的研究人员详细描述了如何将他们开...
Oncotarget:FDA批准药物或可靶向癌症干细胞 抑制复发和转移
2017-01-21化疗药物能够杀死大多数癌细胞,但是癌症干细胞常常可以生存下来并促进新肿瘤的形成。在一项发表在国际学术期刊Oncotarget上的新研究中,索尔福德大学的研究人员发现干细胞的特性和...
Cancer Cell:科学家揭示肺腺癌治疗新靶点 候选药物已进入临床试验阶段
2017-01-21美国梅奥诊所的研究人员发现一个癌基因能够促进肺癌发生。相关研究结果发表在国际学术期刊Cancer Cell上,梅奥诊所的研究人员提供证据表明Ect2能够驱动肺腺癌肿瘤形成。“这篇文章...
PNAS:鉴定出保护乳腺癌起始细胞的蛋白G3BP2
2017-01-21在一项新的研究中,来自美国麻省综合医院(MGH)的研究人员鉴定出一种蛋白可能在维持乳腺癌内的肿瘤起始细胞(tumor-initiating cell, TIC)群体中发挥着不可或缺的作用,并且鉴定出一种化合物...
Nature 子刊:手机摇身一变成为显微镜,对肿瘤进行突变检测
2017-01-21瑞典和美国的研究人员近日设计出一款精巧的显微镜,它可以利用手机上的摄像头来检测 DNA 测序反应的荧光产物,从而实现癌基因的突变分析。这项成果于本周发表在《Nature Communicatio...
Cell:对抗癌症,并不仅仅只是肿瘤免疫细胞的孤军奋战!
2017-01-21根据斯坦福大学医学院科学家对实验室小鼠的一项新研究显示,对抗癌症需要整个身体免疫分子的协同努力,而不仅仅是肿瘤本身。这一研究可以帮助临床医生了解为什么一些癌症患者对癌症免疫治...
“并发性”致死可能为癌症提供新疗法
2017-01-21德克萨斯大学 MD 安德森癌症中心的研究人员于1 月18 日在 Nature 上发表了一项新研究,可能为癌症治疗提供新思路。...
驱肠虫药也能抗癌?重庆医科大学季平教授发表新成果
2017-01-20头颈鳞状细胞癌(HNSCC)是最常见侵袭性最强的人类癌症之一。接近一半的HNSCC 病人在接受治疗后的五年时间内会出现复发,并抵抗化疗药物。因此开发新型安全有效的HNSCC抗癌疗法存在迫...
科学家如何“老药新用”来抗癌?
2017-01-20老药新用,即利用已知药物来治疗非适应症等疾病,近些年来,随着科学家们研究深入,他们常常会在研究中偶然发现有些已经使用了很多年的药物或许能够用来治疗其它多种人类疾病,且效果非常理想,...
中国团队发现:胃肠肿瘤干细胞分化出神经细胞促进肿瘤发展
2017-01-19施普林格自然与华西医院的合作期刊 Signal Transduction and Targeted Therapy(STTT,《信号传导与靶向疗法》)在线发表了四川大学莫显明教授团队的研究性文章 Neurons generated from car...
上交吴方 :肿瘤耐药激酶 AXL 的膜内剪切机制
2017-01-19酪氨酸激酶 RTK(58 种,20 类受体型)是位于细胞膜上的信号转导开关,通过调控其活力已成功发展了多种靶向药物,如抗癌明星药物易瑞沙 Iressa®、特罗凯 Tarceva®、索坦 Sunitinib®、 赫赛汀...
eLife 惊人发现:抗疟药物治愈了 26 岁的癌症患者
2017-01-19然而在科罗拉多大学癌症中心,Lisa 尝试了一种新的药物组合,这稳定住了她的病情,并提高了生活治疗和时间。科学家们和临床医师利用一种对抗疟疾的药物:氯喹(chloroquine)进行治疗,阻止了癌细胞...